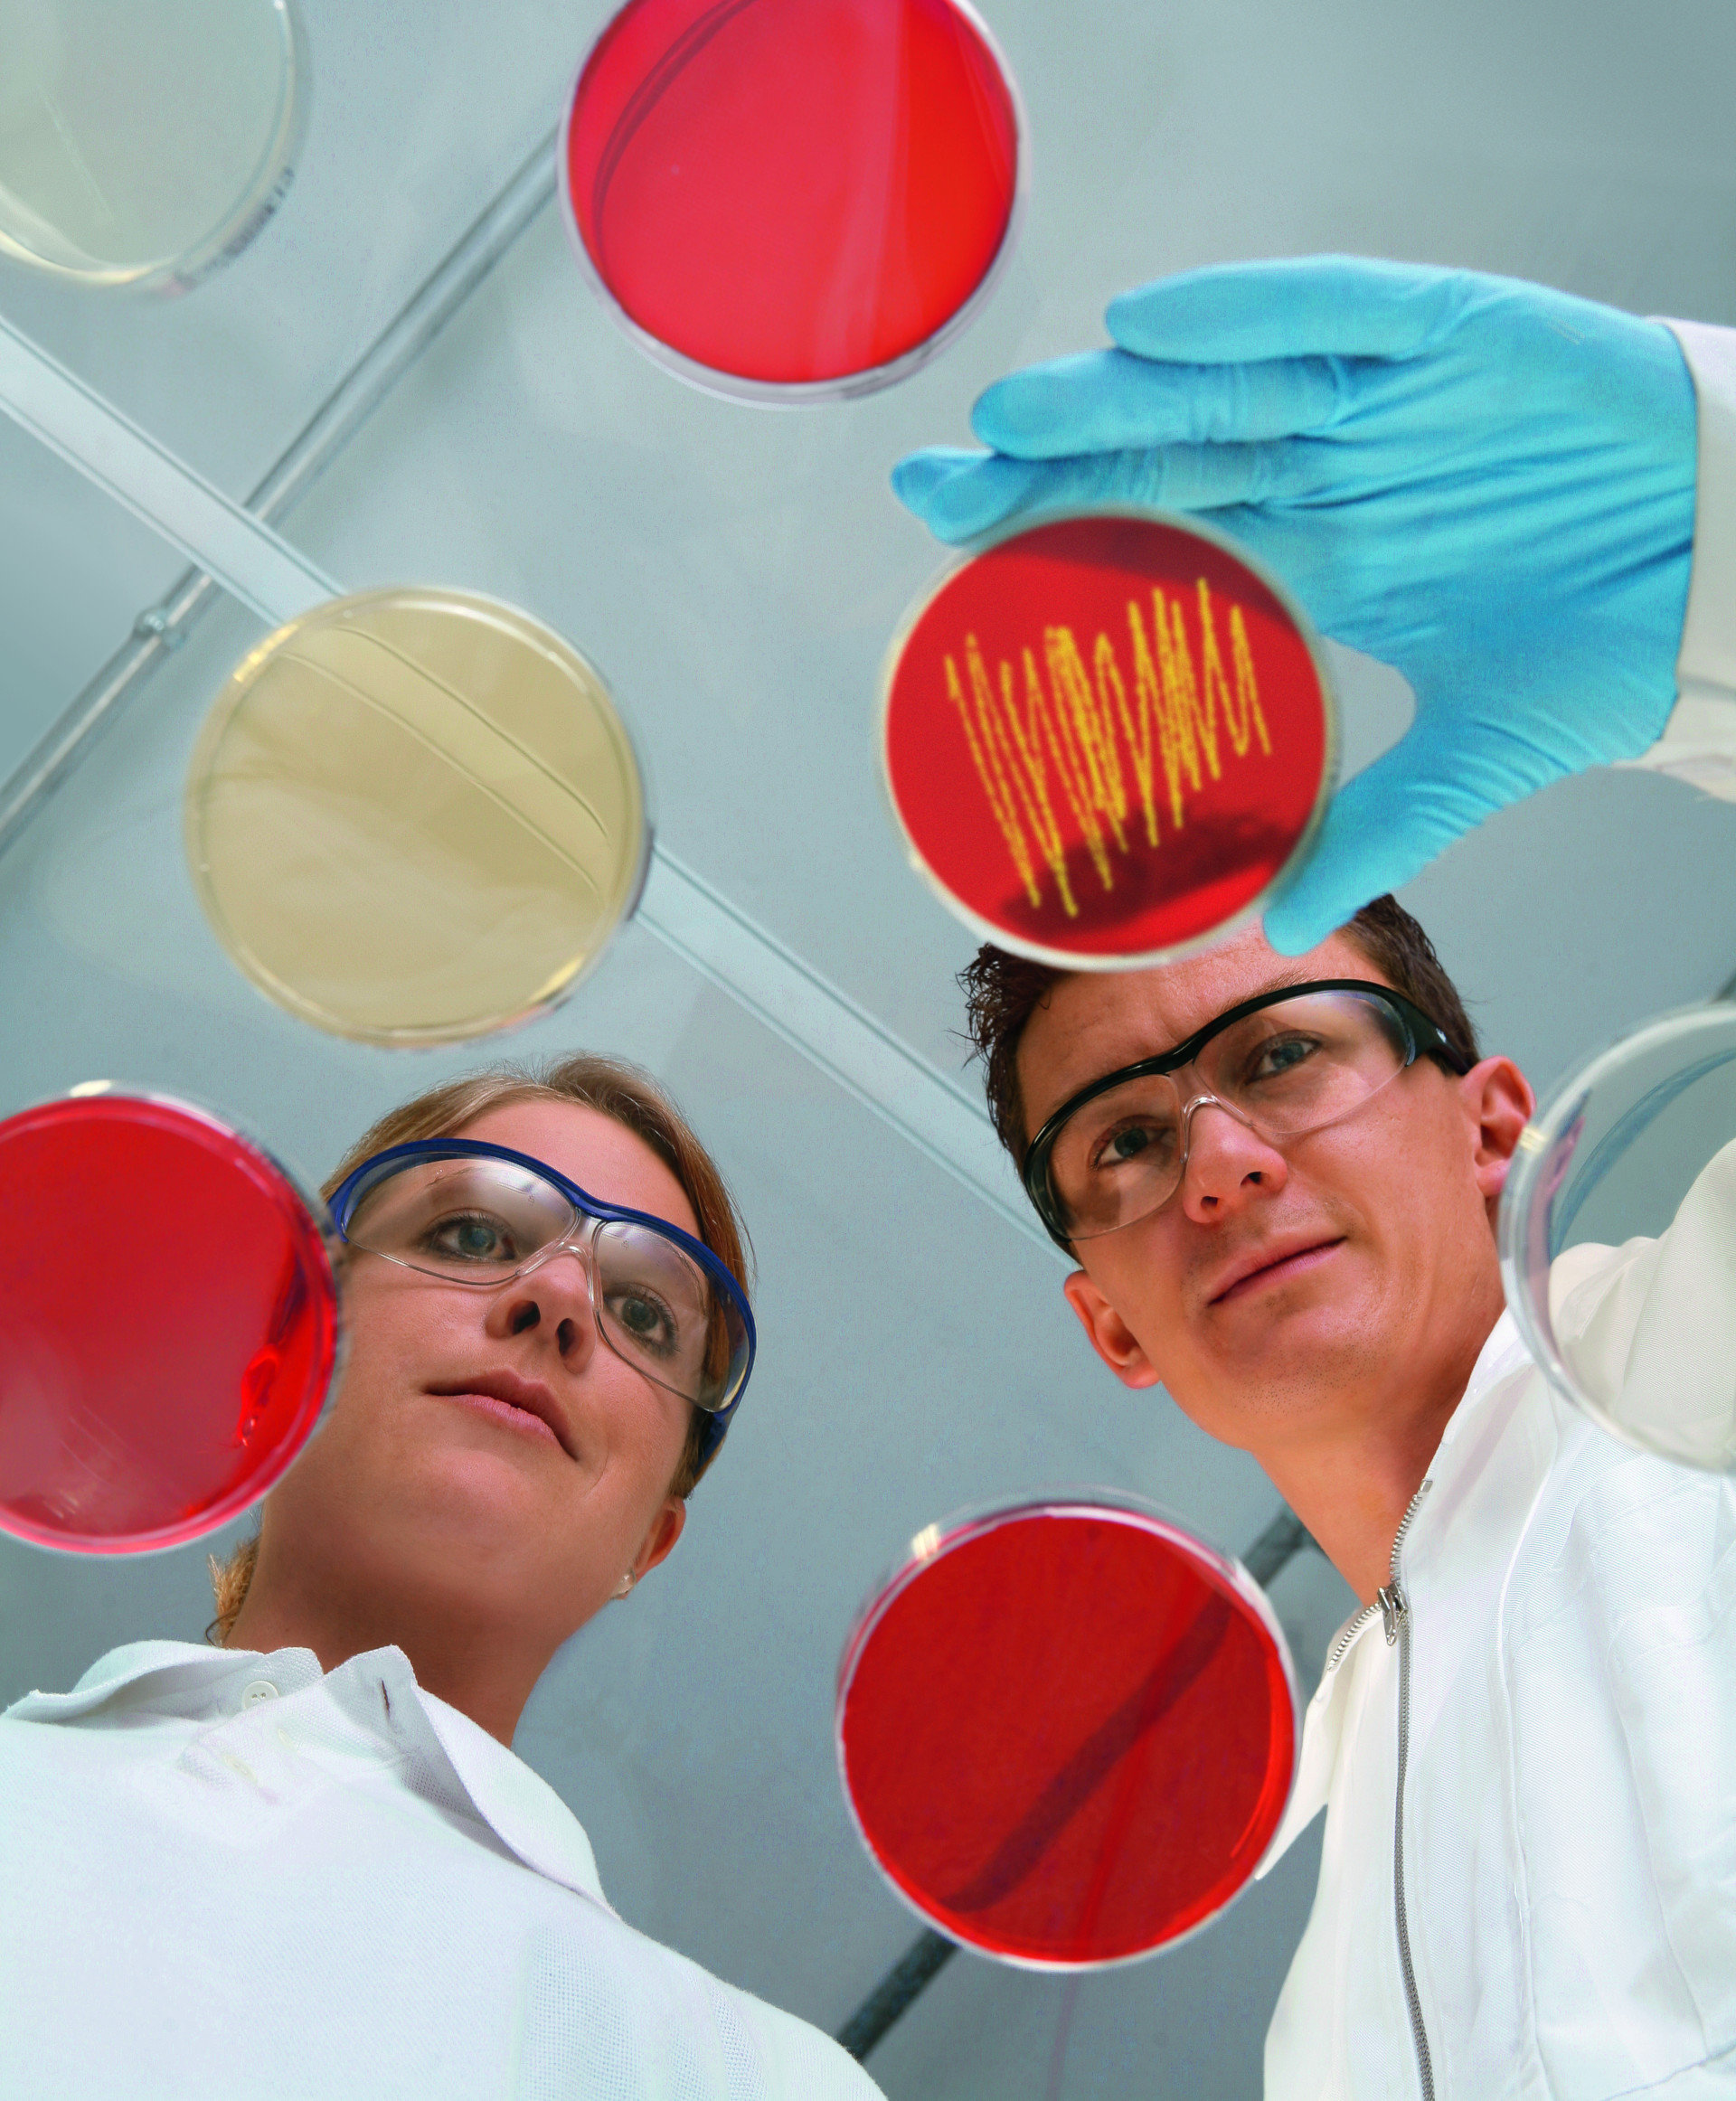

Vision & Mission
Wir sind das führende europäische Cluster für die forschungsbasierte Entwicklung und Herstellung von Biopharmazeutika – regional verankert, global erfolgreich
27
Mitglieder aus Unternehmen, Wissenschaft und Politik
>15K
Fachkräfte arbeiten und forschen im Bereich Life Sciences
>100
Life Science Unternehmen und Forschungseinrichtungen
Der BioPharma Cluster South Germany entwickelt eine attraktive, vielseitige und innovations-getriebene Umgebung für die Forschung, Entwicklung und Produktion von Biopharmazeutika und Therapien.
Durch den Fokus auf Technologie, Fachkräfte und Gesellschaft stärken wir den Gesundheitsstandort insgesamt zum Wohle von Patienten und Patientinnen weltweit.
Einzigartig ist dabei die räumliche Verdichtung von grundlagenorientierten sowie angewandten Forschungseinrichtungen und global erfolgreichen Unternehmen, die alle Teile der biopharmazeutischen Wertschöpfungskette abbilden.